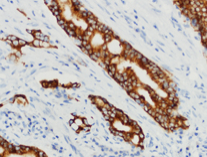

IMP3抗体试剂
IMP3抗体试剂
胰岛素样生长因子 Ⅱ mRNA 结合蛋白3
产品描述
IGF2BP3(IMP-3)抗体 是一种靶向胰岛素样生长因子2 mRNA结合蛋白3的免疫检测工具,该蛋白由IGF2BP3基因编码,通过KH结构域结合RNA并调控胰岛素样生长因子II的翻译抑制。IMP-3在早期胚胎组织中生理性表达,但在多种恶性肿瘤(如非小细胞肺癌、胰腺导管腺癌、肾细胞癌、宫颈腺癌、子宫内膜癌、食管腺癌、恶性黑色素瘤、Merkel细胞癌、尿路上皮癌、肺神经内分泌癌及三阴性乳腺癌)中异常高表达,其阳性率在非小细胞肺癌组织中达74.7%(癌旁组织仅19.9%),且表达与肿瘤侵袭性增强和患者生存期缩短显著相关。该抗体在病理诊断中具有多重价值:①作为恶性标志物辅助胰腺导管腺癌穿刺活检诊断;②通过胞质染色模式评估非小细胞肺癌预后(IMP-3阳性患者无病生存期和总生存期显著降低);③鉴别子宫内膜癌及其癌前病变(尤其在组织量有限时对II型癌症的判断);④值得注意的是,其在妊娠期子宫内膜蜕膜间质和早期绒毛中的高表达需与肿瘤性表达鉴别。
参考文献
产品信息
备案名称:
胰岛素样生长因子 Ⅱ mRNA 结合蛋白3(IMP3)抗体试剂
备案证号:
粤深械备 20221667
产品型号:
DMRD0210
适用:
阳性部位:
细胞质/膜
预 处 理:
产品规格
| 类型 | 即用型 | 浓缩型 | ||||
| 规格 | 1ml | 3ml | 6ml | 10ml | 0.1ml | 0.2ml |


